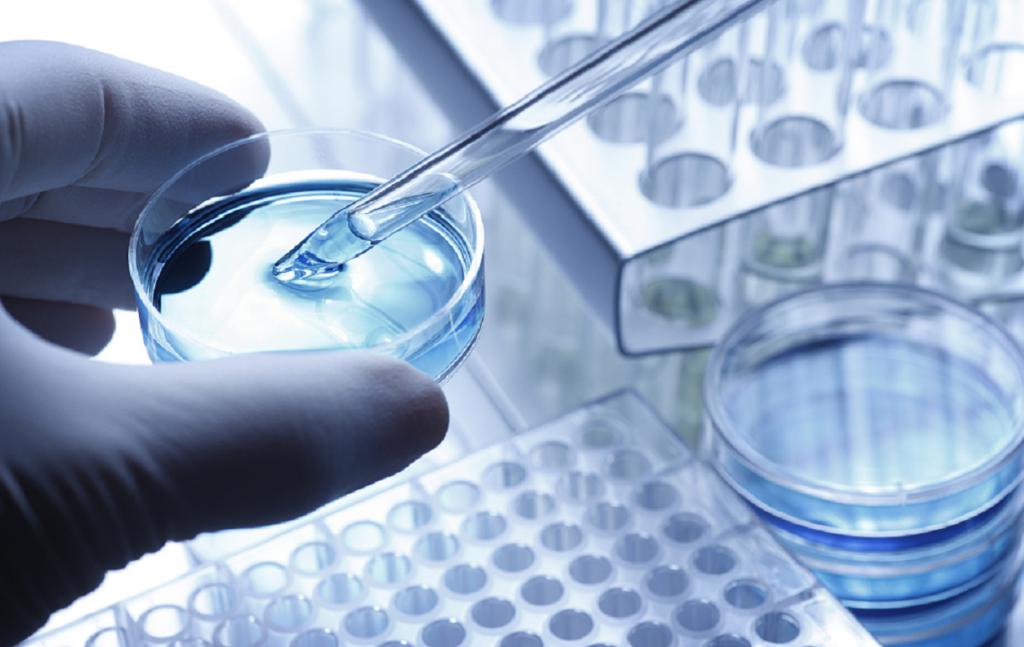

先入咸阳者为王:肺癌黄金靶点 EGFR 的第四次战争
先入咸阳者为王:肺癌黄金靶点 EGFR 的第四次战争
先入咸阳者为王:肺癌黄金靶点 EGFR 的第四次战争
图片来源 @视觉中国
文 | 医曜
肺癌因其超高的发病率和致死率,成为人类的 " 头号杀手 "。依据病理的差异,肺癌主要分为两大类:非小细胞肺癌(NSCLC)和小细胞肺癌,其中 NSCLC 以约 85% 的占比成为肺癌的主流。
尽管 NSCLC 被归结为一大类别,但其发病诱因却有多种类型,如 EGFR、KRAS、c-MET、HER2、ALK 等靶点基因突变。在这些所有的突变中,EGFR 基因以 35% 的突变概率,成为 NSCLC 最核心的战场,尤其在亚洲国家,突变比率更是攀升至 50% 左右。
基于此,EGFR 基因也就成为人类攻克肺癌最优先聚焦的关键靶点。
贝达药业就曾凭借第一代 EGFR 抑制剂埃克替尼的成功,在十年内创下热卖百亿的壮举,这揭示了 EGFR 抑制剂所蕴含的巨大机会。
然而,伴随新一代 EGFR 抑制剂的崛起,埃克替尼等第一代药物正逐渐被边缘化,贝达药业也因此逐渐开始业绩失速。在这样的背景下,EGFR 这一黄金靶点的机会何在?又会否再次诞生如贝达药业一样的 " 业绩奇迹 "?
01 EGFR 靶点诱病之因
想要搞清楚 EGFR 这一黄金靶点所存在的机会,投资者必须先搞清楚它的诱病之因。
所谓 EGFR,全称为表皮生长因子受体,从名称不难看出,这是一个与表皮细胞生长密切相关的受体。EGFR 可以接收生长因子的信号,并向细胞内部传递,从而达到促进细胞生长的目的。由此可见,EGFR 是一个与细胞生长高度相关的受体,当表皮细胞进行分裂时,EGFR 基因就会活跃起来。
在人体中,EGFR 基因起着重要的作用,然而当 EGFR 基因扩增失控时,它又会因过度表达从而让细胞疯狂生长分裂,而这也正是癌细胞的典型表征之一。也就是说,当 EGFR 基因发生 " 异变 " 时,它就诱导细胞疯狂生长,从而诱发正常细胞逐渐转化为癌细胞。
聚焦 EGFR 基因的微观结构,其共由 7 号染色体上的 28 个外显子组成。在这 28 个外显子中,EGFR 基因的 " 异变 " 常发生于 18、19、20、21 这四个外显子之中,尤其是 19 外显子缺失和 21 外显子突变更是分别占据了总突变概率的 45% 和 40%。

图:EGFR 靶点突变情况,来源:山西证券
简单分析可以发现,解决了 19、21 这两个外显子的突变,也就解决了 EGFR 靶点的绝大多数问题,而这也成为了第一代 EGFR 抑制剂的核心思路,只不过现实远比想象中更加残酷。
02 耐药性:EGFR 抑制剂的 " 梦魇 "
第一代 EGFR 抑制剂主要作用于 19、21 这两个外显子,成功抑制了它们的 " 异变 ",曾一度让肺癌患者的预后大幅改善。
在那之前,肺癌患者化疗的平均存活周期约 18 个月,而在第一款 EGFR 抑制剂吉非替尼推出后,让患者生存期大幅提升至 28.7 个月,患者生存质量也得到了大幅改善。
尽管 EGFR 抑制剂取得了显著突破,但有限的疗效依然难以让市场满意,大多数患者都在使用 EGFR 抑制剂一段时间后,就会开始产生耐药性,从而让第一代 EGFR 抑制剂失去疗效。
究其原因,虽然第一代 EGFR 抑制剂解决了 19 和 21 两个外显子的突变问题,但却无法阻止 20 号外显子 T790M 的耐药突变。
耐药性成为 EGFR 抑制剂挥之不去的 " 梦魇 ",如何解决耐药性也成为药企在 EGFR 的核心课题。
03 EGFR 抑制剂的三个代际
EGFR 抑制剂诞生至今,共经历过三个代际,目前阿斯利康的第三代 EGFR 抑制剂奥希替尼已经成为这一靶点的主流,其单年营收已经超过 50.15 亿美元。

图:EGFR 抑制剂市场份额,来源:浙商证券
纵观 EGFR 抑制剂的历史份额,这个行业的主导权实则是由第一代向第三代过渡,第二代 EGFR 抑制剂一直没有成为过市场的主流。究其原因在于,第一代 EGFR 抑制剂的核心问题是 T790M 的耐药性突变,而第二代 EGFR 抑制剂在这一点做得并不好,其只是在某些罕见 EGFR 突变有很好的疗效,同时对鳞癌也有一定的治疗作用。
真正全面解决 T790M 耐药性问题的是第三代 EGFR 抑制剂的奥希替尼,它也成功让肺癌患者的总生存期进一步延长至 38.6 个月。
卓尔不凡的疗效让奥希替尼成为行业 " 效仿 " 的对象,两款已经上市的国内自研第三代 EGFR 抑制剂阿美替尼和伏美替尼实则都是奥希替尼的 "me too" 产品,都是在奥希替尼骨架基础上进行结构修饰而获得的药物,它们的疗效同样与奥希替尼相差并不大。

图:三款第三代 EGFR 抑制剂疗效对比
聚焦国内第三代 EGFR 抑制剂的竞争,进口药奥希替尼作为龙头优势明显,无论是品牌认知度还是价格上,奥希替尼都有明显优势;与之相对,两款国产药物的竞争力则并没有那么强,虽然单盒价格明显低于奥希替尼,但却是数字游戏,患者真正的单日用药价格是要明显高于奥希替尼的。

图:国内第三代 EGFR 抑制剂 2023 年价格,来源:锦缎研究院
在没有价格优势的情况下,两款国产药物想要突围,就必须在营销渠道和政策上下功夫。目前艾力斯的伏美替尼则是最强力的竞争者,根据艾力斯年报,伏美替尼在上市第二年就取得 7.9 亿元的营收,这一数据是要明显强于贝达药业埃克替尼同期营收的(上市第二年营收 3.12 亿元)。
图:埃克替尼与伏美替尼同期营收对比,来源:锦缎研究院
尽管贝达药业的贝福替尼近日已经获批,但考虑到几款已经上市的第三代 EGFR 抑制剂的竞争已经进入白热化,除非贝达药业可以通过头对头试验证明自己,否则竞争环境更加激烈的情况下,贝福替尼可能很难复刻当年埃克替尼的 " 奇迹 "。
04 新的战争已经开启
第三代 EGFR 抑制剂虽然解决了 T790M 耐药性问题,但它本身却又遭遇了新的耐药性麻烦,而且机制也变得更加复杂。具体来看,第三代 EGFR 抑制剂的耐药性共有三种诱因:EGFR 靶点突变、EGFR 下游信号通路激活、组织学转化。
在这三种耐药性突变中,MET、K-RAS 等下游信号激活、组织学转化均可以通过联用其他药物的方式治疗,致使 EGFR 基因 20 号外显子 C797S 的突变再次成为 EGFR 抑制剂所面对的新课题,如何开发新的针对性药物成为第四代 EGFR 抑制剂研发的核心思路。
尤其是对于 C797S 顺式突变的患者,目前临床中并没有行之有效的治疗方案,第四代 EGFR 抑制剂已然成为患者新的希望,就如同当年的 T790M 突变一样,谁能攻克它谁就有希望成为下一款奥希替尼。
现阶段,研发进度最快的为美国生物制药公司 Blueprint 的在研管线 BLU-945,其已经进入到关键性的临床二期阶段,并已经取得一定进展。对于奥希替尼耐药后的肺癌患者,在用药 14 天内,83% 的患者外周血样中 T790M 突变丰度下降,81% 的患者 C797S 突变丰度下降。此外,对于 EGFR 敏感突变(19 和 21 号外显子突变)、T790M 突变、C797S 突变的三重突变细胞,BLU-945 的杀伤力要高出千倍以上。
尽管 BLU-945 距离获批上市还有很长的路要走,但其已经获得再鼎医药的引进,成为国内第四代 EGFR 抑制剂的先行者。除此之外,贝达药业、翰森制药、齐鲁制药、君实生物、正大天晴也均开启第四代 EGFR 抑制剂的研发,但研发进度依然处于临床早期阶段,并没有实质性的进展。
05 先入咸阳者为王
2003 年,第一款靶向药物 EGFR 抑制剂吉非替尼诞生,由此肺癌不再 " 无药可医 "。
尽管历经二十年的耕耘,人类依然没有攻克 EGFR 靶点耐药性的问题,可伴随 EGFR 抑制剂的不断迭代,患者的总生存器已经得到了显著提升。潜移默化之间,EGFR 抑制剂已经逐渐把肺癌变成了一种 " 慢性病 "。
除总生存期的显著延长外,药物的价格也随着技术的精进而大幅降低。以明星药物埃克替尼为例,刚更上市时它的售价约为 3000 元左右一盒,而经历第三代 EGFR 抑制剂的竞争后,埃克替尼的售价已经降至 835 元一盒,降幅高达 72.2%,患者一年用药负担也从最初的约 15 万降至如今的 4.3 万。
对于癌症,绝大多数人都存在一个误区,那就是过于关注如何消灭它。实际上,针对癌症的最佳手段不是消灭,而是将其转化为慢性病。一方面通过药物迭代努力提升患者的生存期,另一方面则通过医改大幅降低患者的用药负担。
如果癌症患者的总生存期足够长,用药负担足够低,那么人类就无需再为了癌症去过分忧愁,这实则才是医药产业发展的意义。
回归投资层面,当我国药企研发的药物行至时代前列,即使与国际一线药物有所差距,但只要竞争格局和药效足够好,它就有望复制贝达药业当年埃克替尼的辉煌。
以目前视角来看,国内第三代 EGFR 抑制剂中,单年销售额已经达到 7.9 亿元的艾力斯无疑最具竞争力;而 " 老霸主 " 贝达药业则依靠埃克替尼的沉淀拥有渠道优势,在贝福替尼上市后或对艾力斯产生冲击。第四代 EGFR 抑制剂方面,再鼎药业则走在时代前沿,但依然需要注意新药研发的不确定性风险。
更多精彩内容,关注钛媒体微信号(ID:taimeiti),或者下载钛媒体 App
-

- 祝闺蜜恋爱祝福语(爱情祝福语10字短句)
-
2026-01-30 09:11:49
-

- 哄女人开心的话幽默情话暖心幽默简短的句子(精选70句)
-
2026-01-30 09:09:34
-

- 表白话语简短30字表白话语简短十字(精选80句)
-
2026-01-30 09:07:20
-

- 情侣个性签名海枯石烂(精选100句)
-
2026-01-30 09:05:05
-

- 给女朋友留言的情话深夜给女朋友留言的情话(精选50句)
-
2026-01-30 09:02:51
-

- 很撩很甜很暖的表白情话(总共77句)
-
2026-01-30 09:00:36
-

- 浪漫爱情的句子,浪漫爱情语句 浪漫爱情语句(精选90句)
-
2026-01-30 08:58:21
-

- qq情侣签名一男一女87句
-
2026-01-28 04:52:16
-

- 高大上的爱情现代句子 爱情公寓经典爱情语录(精选77句)
-
2026-01-28 04:50:02
-

- 精选的想念情人的短信大全(想念情人的短信情话)
-
2026-01-28 04:47:48
-

- 土味情话大全一问一答的套路情话【汇总97句】
-
2026-01-28 04:45:33
-
- 情商高的对话语录
-
2026-01-28 04:43:19
-
- 分手以后放下的话 形容分手后放不下的唯美句子有哪些?
-
2026-01-28 04:41:05
-

- 话高端秀恩爱中的经典爱情语录(精选85句)
-
2026-01-28 04:38:50
-

- 浪漫爱情句子短句 最美的现代爱情句子
-
2026-01-28 04:36:36
-

- 爱情生活格言81句
-
2026-01-28 04:34:21
-

- 有关爱情的表白句子最浪漫简短的表白句子(精选72句)
-
2026-01-28 04:32:07
-

- 经典唯美的爱情伤感句子
-
2026-01-27 09:54:42
-

- 英文经典爱情句子158句
-
2026-01-27 09:52:28
-

- 浪漫爱情的伤感句子
-
2026-01-27 09:50:14



 有趣土味情话高级撩人(100句土味情话短句)
有趣土味情话高级撩人(100句土味情话短句) 发给老公的暧昧短信92句
发给老公的暧昧短信92句